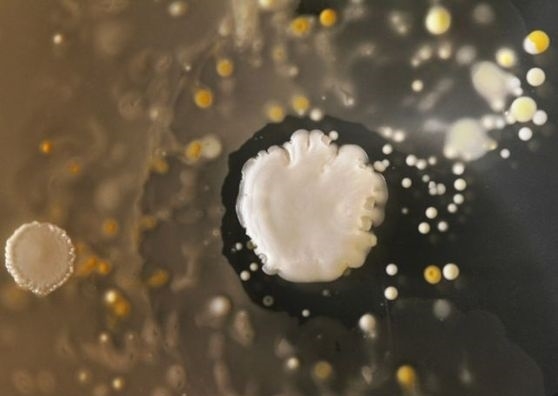
Cep telefonu kullananlar dikkat! galerisi resim 4

Cep telefonu kullananlar dikkat!
01 Nisan 2016 Cuma 15:08Bu bakterilerden kurtulmanın yolu var mı? En iyi yöntem telefonları temiz tutmak ve mümkün olduğu kadar sık silmek. Cep telefonlarında tuvaletlere oranla 18 kat daha fazla bakteri olduğunu belirten uzmanlar, ıslak mendillerin kullanılmasını öneriyor. Cep telefonlarına bakteri bulaştırmamanın yollarından birisi de, tuvalete giderken, telefonu dışarda bırakmak. Bakterilerin çoğu elden telefonlara geçtiği için, ellerin temizliği, telefona yabancı kişilerin dokunmamasına izin vermemek de çözüm olabilir.
Tüm Hakları Saklıdır © 2014 Haberdarım | İzinsiz ve kaynak gösterilmeden yayınlanamaz.
Haber Yazılımı: So Bilişim
Haber Yazılımı: So Bilişim